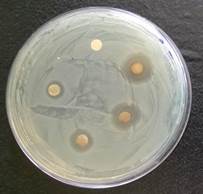
8

Amity Institute of Biotechnology, Amity University Rajasthan, Jaipur
Email: skaushik@jpr.amity.edu
Received: 04 Mar 2016 Revised and Accepted: 17 May 2016
ABSTRACT
Objective: Green synthesis, characterization of silver nanoparticles (AgNPs) and study of the synergistic effect of AgNPs with antibiotic doxycycline against Klebsiella pneumonia.
Methods: AgNps were synthesized from bacteria isolated from samples obtained from petroleum soil. After characterization of the nanoparticles, the antibacterial activity of the nanoparticle was studied, and simultaneously the same nanoparticle was used in combination with doxycycline antibiotic.
Results: It was observed that compared to the effects of AgNps and antibiotic alone, the collective effect on both of them was more evident, which indicate the synergistic effect of the two components.
Conclusion: These findings highlight the potential for AgNPs to enhance the activity of doxycycline antibiotic against Klebsiella pneumonia infections.
Keywords: Silver nanoparticle, Green Synthesis, Klebsiella Pneumonia,Doxycycline
© 2016 The Authors. Published by Innovare Academic Sciences Pvt Ltd. This is an open access article under the CC BY license (http://creativecommons.org/licenses/by/4.0/)
INTRODUCTION
Klebsiella pneumonia is a Gram-negative, facultatively anaerobic, non-motile, rod-shaped bacterium particularly found in human intestines, sewage, water, soils, surface waters, industrial effluents, and vegetation [1, 2]. It causes a wide variety of infections, including pneumonia, bacteremia, meningitis and urinary tract infections [3, 4]. Being a hospital pathogen, Klebsiella pneumonia mainly infects patients in intensive care units and emergency wards of hospitals having weakened immune systems [5, 6]. In the past, it has been reported that the infections caused by the pathogen were of moderate severity; however, the recently increased prevalence of this bacterial infection with serious consequences has been observed due to regular exposure of antibiotics. Klebsiella pneumonia has become resistant to many classes of antibiotics, which have resulted in the production of multidrug-resistant strains [7, 8]. Due to the acquired antibiotic resistance by the bacterium, there is an urgent need to look for an effective alternative. In this regard, it has been observed that the antimicrobial nature of silver and its compounds have been known for a long time, and since then silver has been used for prevention and control of different infections [9, 10]. Silver had also shown a high potential in many biological applications, mainly in the form of nanoparticles [11]. AgNPs are able to interact with the cellular machinery of bacteria. It has been already reported that AgNPs has the ability to damage cell components and cell membranes, causing structural changes, by which bacteria become more permeable [12]. Synthesis of nanoparticle from biological sources is now becoming more and more popular [13, 14]. The main aim of such studies is to reduce the toxic byproducts of chemically synthesized nanoparticles which pollute the environment. Recent past studies have revealed that the antimicrobial effects of silver ions and silver nanoparticles (AgNPs) in combination with commonly used antibiotics was increased as compared to their use separately [14, 15].
Soil samples were collected from petroleum waste. A small amount of soil was suspended in 10μl of sterile distilled water. It was mixed well and kept at 80 ˚C for 10 min. After the incubation, subsequent serial dilutions were prepared and spread onto Luria-Bertani (LB) agar medium. After incubation overnight at 37±2 °C, plates containing an adequate number of colony-forming units (CFUs) were chosen randomly. Bacteria were characterized under the microscope for color, shape, and size. The isolate was Gram and endospore stained and tested for indole, methyl red, Voges-Proskauer and citrate (IMVIC) test and utilization of different sugars (lactose, dextrose, and sucrose) and catalase tests. Multiple bacterial colonies obtained after streaking was used for the preparation of AgNp. A single colony from each plate was picked and inoculated in Luria Broth. The flasks were kept on 200 rpm overnight at 37˚C. The bacterial culture was centrifuged to separate the biomass. The supernatant and cell pellet were collected separately and an equal amount of silver nitrate solution (prepared in deionized water) was added with various concentrations (0.5, 1.0, 1.5, 2.0, 2.5 mM) in both of them separately. After addition of silver nitrate solution both the samples were kept in dark at room temperature. Along with these, a negative control was also maintained under the same conditions containing only the culture without adding silver nitrate in it. The synthesis of AgNps was initially indicated by a color change from pale white to brown. The confirmation of nanoparticle formation was done by UV-VIS spectrophotometer (Thermo Scientific). The UV-VIS absorption spectra of the AgNPs were monitored in a range of 300-800 nm for all the samples used for nanoparticle synthesis. Strong peaks at 420-430 nm were obtained indicating the synthesis of silver nanoparticles. For Fourier-Transform Infra-Red (FTIR) spectroscopy measurements, the solution after the reaction was centrifuged at 6000 rpm for 15 min and the resulting suspension was then resuspended in 15 ml autoclaved distilled water. After this, the purified suspension was lyophilized to get the dried powder. Finally, the dried nanoparticles were analyzed by FTIR (Shimazdu, India). Morphological analysis of AgNPs was done using Transmission Electron Microscopy (TEM), for this a drop of nanoparticles dispersed in water was deposited on a copper grid. The drop was allowed to dry after deposition on the grid. Nanoparticles were then stained with a uranyl acetate (1%, w/v) solution to contrast lipid material, rinsed with distilled water and then analyzed at 100 kV with Philips CM-100 electron microscope. Particle dimensions were measured using Image J software analysis. Luria-Bertani (LB) agar was prepared according to the manufacturer’s instructions. The medium was sterilized by autoclaving at 121 °C for 15 min at 15 psi pressure and was used to determine the antibacterial activity of AgNPs from soil bacteria [16]. The media was allowed to cool and then it was poured carefully onto the sterile petri plates. After solidification of the media, plates were seeded with Klebsiella pneumonia by spreading evenly onto the surface of the medium with a sterile spreader. For antimicrobial activity, filter paper disc was used (8 mm diameter) which were filled with 0.01 ml of the each synthesized silver nanoparticles solution in respective wells. Double distilled water was used as negative control. After addition of nanoparticles onto the filter discs, the plates were kept at 37 °C overnight. The zone of inhibition was measured with a measuring scale. The additive effect of the nanoparticle with doxycycline was also studied by disc diffusion method. Luria-Bertani (LB) agar was prepared and poured into the plates. 0.1 ml of overnight grown bacterial culture was spread onto LB agar. After spreading evenly with Klebsiella pneumonia, filter paper discs were poured with 0.01 ml each of double distilled water only, antibiotic only, nanoparticle only and a mixture of nanoparticle and antibiotic. Double distilled water was taken as a negative control, antibiotic and nanoparticle were used as positive controls and the mixture was the sample to be tested for the synergistic effect of antibiotic and the nanoparticle. All the experiments were done in triplet and representative data have been presented.
Soil samples collected from petroleum waste were used to isolate different microbial strains on a nutrient agar plate. After serial dilution of the samples, uniform plating was done, and many colonies appeared on the plate next day (fig. 1). After the isolation and purification of different colonies, they were screened for the synthesis of AgNPs. Almost 15 dissimilar bacterial strains were used in the study. Bacterial isolate was confirmed as Pseudomonas sp. on the basis of some morphological and biochemical characteristics (table 1). Amongst all the strains used for production of nanoparticle, the one which produced the darkest brown color was used for characterization.
Fig. 1: Different bacterial colonies
Table 1: Morphological and biochemical characteristics of bacterial isolate
Characters |
Isolate |
Morphology |
|
Shape |
Rod |
Size |
Medium |
Gram Stain |
Positive |
Endospore |
Spore forming |
IMVIC |
|
Indole |
- |
Methyl Red |
- |
Voges Proskauer |
- |
Citrate |
+ |
Sugar fermentation |
|
Dextrose |
- |
Lactose |
- |
Sucrose |
- |
Catalase |
+ |
As the bacterial culture was mixed in the aqueous solution of the silver ion complex, it started to change color from yellow to dark brown due to the reduction of silver ion (fig. 2). After addition of silver nitrate, the first indication for the formation of the nanoparticle is the change in color from yellow to dark brown in within 24-36 h.

Fig. 2: Uninoculated media and bacterial culture with 2 mM AgNO3
The synthesis of AgNPs was confirmed by UV-VIS spectrophotometer (Thermo Scientific). The UV-VIS absorption spectra of the AgNPs were observed in a range of 300-800 nm. A strong peak specific for the synthesis of silver nanoparticles was obtained at 420-430 nm.

Fig. 3: OD scan at UV-visible spectra
Fig. 4: TEM analysis of AgNPs
Fig. 5: FTIR analysis of AgNPs
The absorbance spectra of the reaction mixture containing an aqueous solution of 1 mM silver nitrate and the pellet of bacteria after incubation was recorded (fig. 3). Various studies have characterized the shape and size of the silver nanoparticles by TEM [17, 18]. TEM analysis was also done to characterize the nanoparticles further and it was found that all synthesized AgNPs were spherical in shape with a size less than 50 nm (fig. 4) and found to be well dispersed in an aqueous medium. FTIR analysis was also done for the characterization of silver nanoparticles. FTIR absorption spectrum of silver nanoparticle powder is shown in fig. (fig. 5). Absorbance bands analysis in bio reduction and absorbed in the regions is 1654.25, 1384.65, 1079.80, 3415.14 cm-1.
The antimicrobial activity of the synthesized silver nanoparticles was tested against Klebsiella pneumonia. As indicated from the observations, the zone of inhibition increased with the increase in the concentration of silver nanoparticles (fig. 6). The antibacterial activity against the test bacteria was measured by measuring the diameter of the zone of inhibition of each well. According to the observations, the reaction mixture containing silver nanoparticles exhibited antimicrobial activity against the test bacteria. When tested together, the combination of antibiotic and nanoparticles worked in an effective manner and the combination showed a synergistic effect against Klebsiella pneumonia. Doxycycline was added in combination with AgNPs separately. Enhancement of antibacterial activity of doxycycline was observed by measuring the diameter of the zone of inhibition of the combined antibiotics with the nanoparticles. The overall result is shown in fig. 7.
Klebsiella pneumoniae is a Gram-negative bacterial pathogen which causes a large number of infections. Over the past decade, multidrug-resistant strains of Klebsiella pneumoniae developed and acquired resistance to almost all antibiotics. Silver is known to have antimicrobial properties for a long time. Due to increasing antibiotic resistance, silver has regained interest as an antimicrobial agent [19]. It is previously reported that the antimicrobial activity of AgNPs is more than the antimicrobial activity of silver metal alone [20]. AgNPs show better antimicrobial activity against Gram-negative bacteria as compared to Gram-positive bacteria [21].
Fig. 6: Antimicrobial activity of silver nanoparticles

Fig. 7: Bar diagram showing zone of inhibition (mm) of AgNPs, doxycycline and AgNPs+doxycycline both
It has been observed that Gram-positive bacteria have a thick cell wall as compared to the Gram-negative bacteria which makes difficult for AgNPs to get inside the cell. In the present study, we have studied the combined effects of AgNPs with doxycycline against Klebsiella pneumoniae bacteria using the disc-diffusion method. Most of the usual antibiotics act by initially penetrating into bacteria, which is followed by interaction with its genetic material or sometimes blocking the cell division. Doxycycline which was used in the current study also has a similar mode of action. The combined effect of AgNPs and doxycycline was notably exhibited against Klebsiella pneumonia. These findings are in agreement with the previously reported results of Naqvi et al. [16] and Birla et al. [22]. In these studies, the antibiotic effect of the antibiotic increased when used in combination with AgNPs. The exact mode of action of AgNPs is still under investigation; however, a number of studies have been conducted to find it [23, 24]. It has been assumed that AgNPs disrupt the cell wall formation in the bacteria, or they cause damage to the cellular proteins or the nitrogenous bases [25]. The antibacterial effect of doxycycline in combination with AgNPs is enhanced due to the fact that doxycycline-AgNPs complex is formed in which an AgNP is surrounded by doxycycline molecules. As a result of this, the effective number of molecules of doxycycline present at the site of action increased.
CONFLICT OF INTERESTS
Declared none
REFERENCES